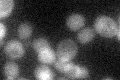
YOR163W
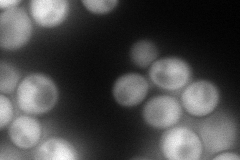
YOR163W
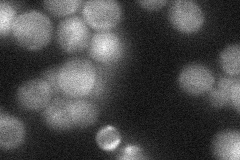
YOR163W
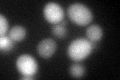
YOR163W
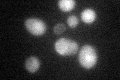
YOR163W

View description
Polyphosphate phosphatase; hydrolyzes diphosphorylated inositol polyphosphates and diadenosine polyphosphates; has high specificity for diadenosine hexa- and pentaphosphates; member of the MutT family of nucleotide hydrolases
Localization:
Intensity:
Fold change:
Significance:
-
C’ GFP library in SD
cytosol33.42 -
N' NOP1pr-GFP in SD
cytosol170.666 -
N' TEF2pr-mCherry in SD

cytosol236.029 -
N' NATIVEpr-GFP in SD
cytosol31.5308 -
N' TEF2pr-VC and Cyto-VN in SD

#N/A0 -
C’ GFP library in SD+DTT
cytosol40.561.21No -
C’ GFP library in SD+H2O2

cytosol45.081.34Yes -
C’ GFP library in Starvation Media
cytosol59.631.78Yes -
C’ GFP library on the background of Pup2-DaMP

cytosol -
C’ GFP library on the background of CCT mutant

cytosol33.11770.990795No
